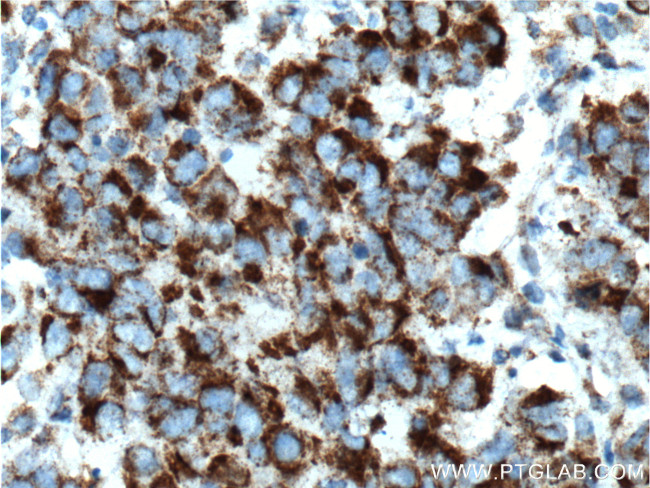
TBXA2R Antibody in Immunohistochemistry (Paraffin) (IHC (P))
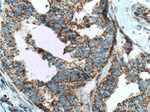
TBXA2R Antibody in Immunohistochemistry (Paraffin) (IHC (P))
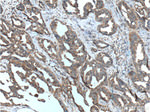
TBXA2R Antibody in Immunohistochemistry (Paraffin) (IHC (P))

Search
Proteintech
TBXA2R Polyclonal Antibody
{{$productOrderCtrl.translations['antibody.pdp.commerceCard.promotion.promotions']}}
{{$productOrderCtrl.translations['antibody.pdp.commerceCard.promotion.viewpromo']}}
{{$productOrderCtrl.translations['antibody.pdp.commerceCard.promotion.promocode']}}: {{promo.promoCode}} {{promo.promoTitle}} {{promo.promoDescription}}. {{$productOrderCtrl.translations['antibody.pdp.commerceCard.promotion.learnmore']}}
产品信息
27159-1-AP
种属反应
宿主/亚型
分类
类型
抗原
偶联物
形式
浓度
规格
纯化类型
保存液
内含物
保存条件
运输条件
靶标信息
The thromboxane A2 receptor (TBXA2R) is a member of the Prostanoid Receptor subfamily. TBXA2R performs an essential role in hemostasis by interacting with thromboxane A2 to induce platelet aggregation. Thromboxane A2 has been implicated in myocardial infarct, stroke, and asthma. Additionally, thromboxane-prostanoid receptors have been implicated in the pathogenesis of cardiovascular diseases. Changes in TBXA2R function have also been linked to a hereditary bleeding disorder.
仅用于科研。不用于诊断过程。未经明确授权不得转售。
生物信息学
蛋白别名: G-protein coupled receptor; TBXA2R; Prostanoid TP receptor; Thromboxane A2 receptor; thromboxane prostanoid; TXA2 receptor; TXA2-R
基因别名: BDPLT13; TBXA2R; TP; TXA2-R
UniProt ID: (Human) P21731, (Mouse) P30987
Entrez Gene ID: (Human) 6915, (Mouse) 21390